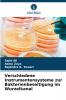
Verschiedene Instrumentensysteme zur Bakterienbeseitigung im Wurzelkanal

German
Paperback
₹5704
₹6273
9.07% OFF
(All inclusive*)
Delivery Options
Please enter pincode to check delivery time.
*COD & Shipping Charges may apply on certain items.
Review final details at checkout.
Looking to place a bulk order? SUBMIT DETAILS
About The Book
Description
Author(s)
Pathologische Veränderungen in der Pulpa und im periradikulären Gewebe sind auf Mikroorganismen und deren Stoffwechselprodukte zurückzuführen. Um eine optimale Heilung des periradikulären Gewebes und eine bessere Prognose der endodontischen Behandlung zu erreichen ist die vollständige Beseitigung von Mikroorganismen deren Stoffwechselprodukten und infiziertem Gewebe das Hauptziel der endodontischen Therapie. Mechanische Instrumente antimikrobielle Spülungen und intrakanaläre Medikamente sind die gängigen Methoden zur Beseitigung der mikrobiellen Belastung im Wurzelkanal. Mechanische Instrumente sind jedoch nach wie vor das Hauptmittel zur Desinfektion des Wurzelkanals da sie eine Grundlage für die beiden anderen Methoden bilden. Seit ihrer Einführung in der Endodontie vor fast zwei Jahrzehnten wurden kontinuierliche Weiterentwicklungen bei den Nickel-Titan-Rotationsinstrumenten vorgenommen. ProTaper Next K3XF und Hyflex CM sind kürzlich eingeführte rotierende Instrumente die durch thermomechanische Behandlung von NiTi-Legierungen hergestellt werden. Das Ziel der vorliegenden Studie war es die Wirksamkeit dieser rotierenden NiTi-Systeme und manuellen Instrumente Hero Shaper und Nitiflex-Feile bei der Reduzierung der Enterococcus faecalis-Population in Wurzelkanälen zu bewerten.
Delivery Options
Please enter pincode to check delivery time.
*COD & Shipping Charges may apply on certain items.
Review final details at checkout.
Details
ISBN 13
9786209213762
Publication Date
-06-11-2025
Pages
-52
Weight
-85 grams
Dimensions
-152x229x3.16 mm